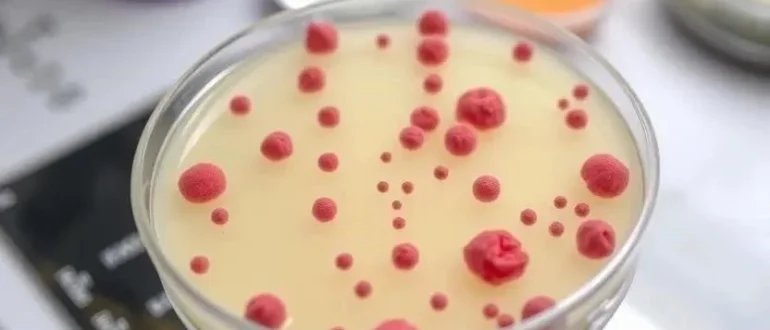

Болезни растений
Чувствуете усталость, проблемы с кожей или ломкость ногтей после болезни? Узнайте, как инфекции влияют на гормоны и как восстановить баланс! Гормональный сбой – это реально.
Заметили странные пятна на листьях? Узнайте, как распознать и победить бактериальные инфекции растений! Советы по профилактике и лечению, чтобы ваш сад был здоров.
Пятна на листьях, гниющие стебли? Ваши растения могут быть заражены бактериями! Узнайте, как распознать и вылечить болезни комнатных растений, чтобы вернуть им здоровье и красоту.
Листья в пятнах, стебли гниют? Это может быть бактериоз! Узнайте, как распознать и вылечить опасные бактериальные инфекции комнатных растений, чтобы вернуть им здоровье.
Узнай все о бактериальных инфекциях: причины, симптомы, профилактика и современные методы лечения. Не дай бактериям шанса! Заботься о здоровье.
Узнайте, как бактерии атакуют сердце! Инфекционный эндокардит и миокардит – опасные заболевания. Симптомы, причины, современное лечение и профилактика для здоровья вашего сердца.
Узнайте все о бактериальном вагинозе! Причины возникновения, как распознать симптомы и эффективные методы лечения для женского здоровья. Защитите свою репродуктивную функцию!
Узнайте, как обычные бактериальные инфекции могут влиять на ваше психическое здоровье! Долгосрочные психологические последствия, связь бактерий и мозга – все в статье.
Листья в пятнах? Растение увядает? Узнайте, как распознать и победить бактериальные инфекции растений! Советы по лечению и профилактике.
Узнайте все о бактериальных инфекциях уха (отите): причины появления, симптомы, эффективные методы лечения и как предотвратить боль в ухе. Защитите свой слух!